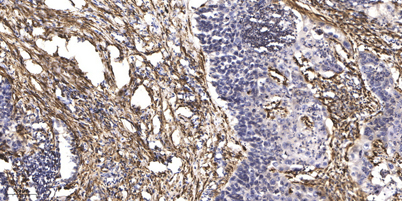

Aurora A Rabbit pAb
 One-click to copy product information
One-click to copy product information$148.00/50µL $248.00/100µL
| 50 µL | $148.00 |
| 100 µL | $248.00 |
Overview
| Product name: | Aurora A Rabbit pAb |
| Reactivity: | Human; Mouse;Rat |
| Alternative Names: | Aurora kinase A (EC 2.7.11.1) (Aurora 2) (Aurora/IPL1-related kinase 1) (ARK-1) (Aurora-related kinase 1) (hARK1) (Breast tumor-amplified kinase) (Serine/threonine-protein kinase 15) (Serine/threonine-protein kinase 6) (Serine/threonine-protein kinase aurora-A) |
| Source: | Rabbit |
| Dilutions: | IHC-p1:50-200 ,WB 1:1000-2000 |
| Immunogen: | Synthesized peptide derived from human Aurora A AA range: 65-115 |
| Storage: | -20°C/1 year |
| Clonality: | Polyclonal |
| Isotype: | IgG |
| Concentration: | 1 mg/ml |
| Observed Band: | 46kD |
| GeneID: | 6790 |
| Human Swiss-Prot No: | O14965 |
| Cellular localization: | Cytoplasm, cytoskeleton, microtubule organizing center, centrosome . Cytoplasm, cytoskeleton, spindle pole . Cytoplasm, cytoskeleton, cilium basal body . Cytoplasm, cytoskeleton, microtubule organizing center, centrosome, centriole . Cell projection, neuron projection . Detected at the neurite hillock in developing neurons (By similarity). Localizes at the centrosome in mitotic cells from early prophase until telophase, but also localizes to the spindle pole MTs from prophase to anaphase (PubMed:9606188, PubMed:17229885, PubMed:21225229). Colocalized with SIRT2 at centrosome (PubMed:22014574). Moves to the midbody during both telophase and cytokinesis (PubMed:17726514). Associates with both the pericentriolar material (PCM) and centrioles (PubMed:22014574). The localization to the spindle |
| Background: | Aurora A(AURKA) Homo sapiens The protein encoded by this gene is a cell cycle-regulated kinase that appears to be involved in microtubule formation and/or stabilization at the spindle pole during chromosome segregation. The encoded protein is found at the centrosome in interphase cells and at the spindle poles in mitosis. This gene may play a role in tumor development and progression. A processed pseudogene of this gene has been found on chromosome 1, and an unprocessed pseudogene has been found on chromosome 10. Multiple transcript variants encoding the same protein have been found for this gene. |
-
 Western blot analysis of 1)HepG2 Cell, 2) Hela Cells treated with Nocodazole using Rabbit pAb diluted at 1:2,000.
Western blot analysis of 1)HepG2 Cell, 2) Hela Cells treated with Nocodazole using Rabbit pAb diluted at 1:2,000. -
Immunohistochemical analysis of paraffin-embedded human Squamous cell carcinoma of lung. 1, Antibody was diluted at 1:200(4° overnight). 2, Tris-EDTA,pH9.0 was used for antigen retrieval. 3,Secondary antibody was diluted at 1:200(room temperature, 45min).
Immunohistochemical analysis of paraffin-embedded human Squamous cell carcinoma of lung. 1, Antibody was diluted at 1:200(4° overnight). 2, Tris-EDTA,pH9.0 was used for antigen retrieval. 3,Secondary antibody was diluted at 1:200(room temperature, 45min).

 Manual
Manual